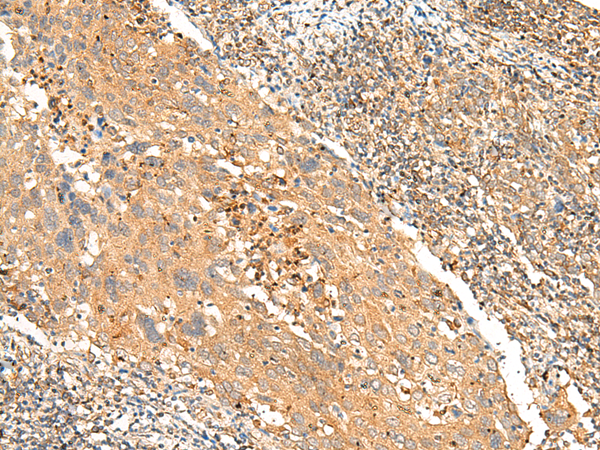

|
Background: |
Orphan receptor. |
|
Applications: |
ELISA, WB, IHC |
|
Name of antibody: |
GPR146 |
|
Immunogen: |
Synthetic peptide of human GPR146 |
|
Full name: |
G protein-coupled receptor 146 |
|
Synonyms: |
PGR8 |
|
SwissProt: |
Q96CH1 |
|
ELISA Recommended dilution: |
5000-10000 |
|
IHC positive control: |
Human cervical cancer and Human liver cancer |
|
IHC Recommend dilution: |
30-150 |
|
WB Predicted band size: |
36 kDa |
|
WB Positive control: |
A172 cell lysate |
|
WB Recommended dilution: |
200-1000 |

購物車
購物車 幫助
幫助
 021-54845833/15800441009
021-54845833/15800441009
